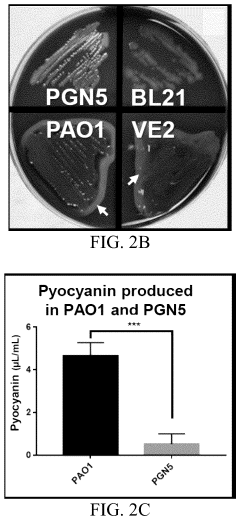

How Sodium Alginate Accelerates Biocompatible Polymer Developments?
JUL 14, 20259 MIN READ
Generate Your Research Report Instantly with AI Agent
Patsnap Eureka helps you evaluate technical feasibility & market potential.
Sodium Alginate in Biocompatible Polymers: Background and Objectives
Sodium alginate, a naturally derived polysaccharide extracted from brown seaweed, has emerged as a pivotal component in the development of biocompatible polymers. This versatile material has garnered significant attention in the biomedical field due to its unique properties and potential applications. The evolution of sodium alginate in biocompatible polymer research can be traced back to the mid-20th century, with initial studies focusing on its gel-forming capabilities and biocompatibility.
Over the past few decades, the utilization of sodium alginate in biomedical applications has expanded dramatically. Its ability to form hydrogels under mild conditions, coupled with its excellent biocompatibility and biodegradability, has made it an attractive candidate for tissue engineering, drug delivery systems, and wound healing applications. The growing interest in regenerative medicine and personalized healthcare has further accelerated research into sodium alginate-based biocompatible polymers.
The primary objective of incorporating sodium alginate into biocompatible polymer developments is to enhance the overall performance and functionality of biomaterials. Researchers aim to leverage its unique properties to create advanced materials that can better mimic natural tissues, provide controlled release of therapeutic agents, and support cell growth and differentiation. Additionally, the goal is to develop novel composite materials that combine the benefits of sodium alginate with other biocompatible polymers or nanoparticles to achieve synergistic effects.
Another crucial objective is to overcome the limitations associated with traditional biocompatible polymers. Sodium alginate offers potential solutions to challenges such as poor mechanical properties, limited cell adhesion, and inadequate degradation profiles. By incorporating sodium alginate, researchers seek to develop materials with improved mechanical strength, enhanced cell-material interactions, and tunable degradation rates.
The integration of sodium alginate in biocompatible polymer research also aligns with the broader trend towards sustainable and eco-friendly materials in healthcare. As a naturally derived polymer, sodium alginate presents an environmentally friendly alternative to synthetic polymers, addressing growing concerns about the environmental impact of medical devices and implants.
Looking ahead, the field of sodium alginate-based biocompatible polymers is poised for significant advancements. Emerging technologies such as 3D bioprinting and microfluidics are expected to further expand the applications of these materials. The ultimate goal is to develop a new generation of biomaterials that can revolutionize regenerative medicine, drug delivery, and tissue engineering, ultimately improving patient outcomes and quality of life.
Over the past few decades, the utilization of sodium alginate in biomedical applications has expanded dramatically. Its ability to form hydrogels under mild conditions, coupled with its excellent biocompatibility and biodegradability, has made it an attractive candidate for tissue engineering, drug delivery systems, and wound healing applications. The growing interest in regenerative medicine and personalized healthcare has further accelerated research into sodium alginate-based biocompatible polymers.
The primary objective of incorporating sodium alginate into biocompatible polymer developments is to enhance the overall performance and functionality of biomaterials. Researchers aim to leverage its unique properties to create advanced materials that can better mimic natural tissues, provide controlled release of therapeutic agents, and support cell growth and differentiation. Additionally, the goal is to develop novel composite materials that combine the benefits of sodium alginate with other biocompatible polymers or nanoparticles to achieve synergistic effects.
Another crucial objective is to overcome the limitations associated with traditional biocompatible polymers. Sodium alginate offers potential solutions to challenges such as poor mechanical properties, limited cell adhesion, and inadequate degradation profiles. By incorporating sodium alginate, researchers seek to develop materials with improved mechanical strength, enhanced cell-material interactions, and tunable degradation rates.
The integration of sodium alginate in biocompatible polymer research also aligns with the broader trend towards sustainable and eco-friendly materials in healthcare. As a naturally derived polymer, sodium alginate presents an environmentally friendly alternative to synthetic polymers, addressing growing concerns about the environmental impact of medical devices and implants.
Looking ahead, the field of sodium alginate-based biocompatible polymers is poised for significant advancements. Emerging technologies such as 3D bioprinting and microfluidics are expected to further expand the applications of these materials. The ultimate goal is to develop a new generation of biomaterials that can revolutionize regenerative medicine, drug delivery, and tissue engineering, ultimately improving patient outcomes and quality of life.
Market Analysis for Sodium Alginate-Based Biocompatible Materials
The market for sodium alginate-based biocompatible materials has experienced significant growth in recent years, driven by increasing demand in various sectors, particularly in the healthcare and pharmaceutical industries. This natural polysaccharide, derived from brown seaweed, has gained prominence due to its unique properties, including biocompatibility, biodegradability, and versatility in forming hydrogels.
In the healthcare sector, sodium alginate-based materials have found extensive applications in wound dressing, tissue engineering, and drug delivery systems. The global wound care market, a key driver for sodium alginate materials, is projected to reach substantial value in the coming years, with a notable portion attributed to advanced wound dressings incorporating alginate-based products.
The pharmaceutical industry has also embraced sodium alginate for its potential in controlled drug release systems and as an excipient in various formulations. The increasing focus on personalized medicine and targeted drug delivery has further boosted the demand for alginate-based materials in this sector.
Emerging applications in the food and beverage industry, particularly in functional foods and nutraceuticals, have opened new avenues for market growth. Sodium alginate's ability to form gels and act as a stabilizer has made it a popular choice in food product development, especially in the context of growing consumer interest in natural and plant-based ingredients.
The cosmetics and personal care industry has also shown increasing interest in sodium alginate-based materials, leveraging their moisturizing and texturizing properties. This trend aligns with the rising consumer preference for natural and sustainable beauty products.
Geographically, North America and Europe currently dominate the market for sodium alginate-based biocompatible materials, owing to advanced healthcare infrastructure and robust research and development activities. However, the Asia-Pacific region is expected to witness the fastest growth, driven by increasing healthcare expenditure, growing awareness of advanced wound care products, and a burgeoning pharmaceutical industry.
Key market challenges include the variability in raw material quality and supply, as well as competition from synthetic alternatives. However, ongoing research into standardization of alginate properties and exploration of new sources could address these challenges, potentially expanding market opportunities.
In the healthcare sector, sodium alginate-based materials have found extensive applications in wound dressing, tissue engineering, and drug delivery systems. The global wound care market, a key driver for sodium alginate materials, is projected to reach substantial value in the coming years, with a notable portion attributed to advanced wound dressings incorporating alginate-based products.
The pharmaceutical industry has also embraced sodium alginate for its potential in controlled drug release systems and as an excipient in various formulations. The increasing focus on personalized medicine and targeted drug delivery has further boosted the demand for alginate-based materials in this sector.
Emerging applications in the food and beverage industry, particularly in functional foods and nutraceuticals, have opened new avenues for market growth. Sodium alginate's ability to form gels and act as a stabilizer has made it a popular choice in food product development, especially in the context of growing consumer interest in natural and plant-based ingredients.
The cosmetics and personal care industry has also shown increasing interest in sodium alginate-based materials, leveraging their moisturizing and texturizing properties. This trend aligns with the rising consumer preference for natural and sustainable beauty products.
Geographically, North America and Europe currently dominate the market for sodium alginate-based biocompatible materials, owing to advanced healthcare infrastructure and robust research and development activities. However, the Asia-Pacific region is expected to witness the fastest growth, driven by increasing healthcare expenditure, growing awareness of advanced wound care products, and a burgeoning pharmaceutical industry.
Key market challenges include the variability in raw material quality and supply, as well as competition from synthetic alternatives. However, ongoing research into standardization of alginate properties and exploration of new sources could address these challenges, potentially expanding market opportunities.
Current Challenges in Biocompatible Polymer Development
The development of biocompatible polymers faces several significant challenges that hinder their widespread adoption and application in medical and pharmaceutical fields. One of the primary obstacles is achieving optimal biocompatibility while maintaining desired mechanical properties. Many polymers that exhibit excellent biocompatibility often lack the necessary strength or flexibility required for specific medical applications, such as implants or tissue scaffolds.
Another major challenge lies in the controlled degradation of biocompatible polymers. Achieving a predictable and consistent degradation rate that matches the healing or regeneration process of the surrounding tissue is crucial. However, factors such as pH, enzyme activity, and mechanical stress can significantly affect degradation kinetics, making it difficult to design polymers with precise degradation profiles.
The scalability and cost-effectiveness of biocompatible polymer production also present significant hurdles. Many promising biocompatible polymers are currently produced at laboratory scales, but transitioning to large-scale manufacturing while maintaining consistent quality and properties remains challenging. This issue is particularly pronounced for complex, bio-based polymers that require sophisticated synthesis processes.
Sterilization of biocompatible polymers without compromising their properties is another critical challenge. Traditional sterilization methods, such as high-temperature autoclaving or gamma irradiation, can alter the polymer's structure, leading to changes in mechanical properties or degradation rates. Developing sterilization techniques that are effective yet gentle on the polymer structure is essential for ensuring the safety and efficacy of medical devices and implants.
The regulatory landscape for biocompatible polymers is complex and evolving, posing additional challenges for developers. Stringent approval processes and varying regulations across different countries can significantly delay the introduction of new biocompatible polymers to the market. Moreover, demonstrating long-term safety and efficacy through extensive clinical trials is both time-consuming and costly.
Lastly, the integration of bioactive molecules or drugs into biocompatible polymers for controlled release applications remains a significant challenge. Ensuring the stability of these bioactive components during polymer processing and storage, while also achieving the desired release kinetics in vivo, requires sophisticated engineering approaches and extensive optimization.
Another major challenge lies in the controlled degradation of biocompatible polymers. Achieving a predictable and consistent degradation rate that matches the healing or regeneration process of the surrounding tissue is crucial. However, factors such as pH, enzyme activity, and mechanical stress can significantly affect degradation kinetics, making it difficult to design polymers with precise degradation profiles.
The scalability and cost-effectiveness of biocompatible polymer production also present significant hurdles. Many promising biocompatible polymers are currently produced at laboratory scales, but transitioning to large-scale manufacturing while maintaining consistent quality and properties remains challenging. This issue is particularly pronounced for complex, bio-based polymers that require sophisticated synthesis processes.
Sterilization of biocompatible polymers without compromising their properties is another critical challenge. Traditional sterilization methods, such as high-temperature autoclaving or gamma irradiation, can alter the polymer's structure, leading to changes in mechanical properties or degradation rates. Developing sterilization techniques that are effective yet gentle on the polymer structure is essential for ensuring the safety and efficacy of medical devices and implants.
The regulatory landscape for biocompatible polymers is complex and evolving, posing additional challenges for developers. Stringent approval processes and varying regulations across different countries can significantly delay the introduction of new biocompatible polymers to the market. Moreover, demonstrating long-term safety and efficacy through extensive clinical trials is both time-consuming and costly.
Lastly, the integration of bioactive molecules or drugs into biocompatible polymers for controlled release applications remains a significant challenge. Ensuring the stability of these bioactive components during polymer processing and storage, while also achieving the desired release kinetics in vivo, requires sophisticated engineering approaches and extensive optimization.
Existing Sodium Alginate-Based Biocompatible Polymer Solutions
01 Sodium alginate in drug delivery systems
Sodium alginate is used in various drug delivery systems to accelerate the release or absorption of active ingredients. It can form hydrogels or microspheres that respond to pH changes, allowing for controlled release of drugs in specific environments. This property is particularly useful for oral and topical formulations.- Sodium alginate in drug delivery systems: Sodium alginate is used in various drug delivery systems to accelerate the release or absorption of active ingredients. It can form hydrogels or microspheres that respond to environmental changes, allowing for controlled release of drugs. This property is particularly useful in oral, topical, and injectable formulations.
- Sodium alginate in wound healing applications: Sodium alginate is utilized in wound dressings and healing applications to accelerate the healing process. It can absorb wound exudates, maintain a moist environment, and promote tissue regeneration. Some formulations combine sodium alginate with other bioactive compounds to enhance its healing properties.
- Sodium alginate in food and beverage industry: In the food and beverage industry, sodium alginate is used to accelerate various processes such as spherification, gelation, and stabilization. It can improve texture, increase viscosity, and enhance the overall quality of products. Its rapid gelling properties are particularly useful in molecular gastronomy and innovative food preparations.
- Sodium alginate in 3D bioprinting and tissue engineering: Sodium alginate is employed in 3D bioprinting and tissue engineering to accelerate the formation of complex tissue structures. Its quick gelation properties allow for rapid solidification of bioinks, enabling the creation of intricate scaffolds for cell growth and tissue regeneration. This application is particularly promising in regenerative medicine and organ transplantation research.
- Sodium alginate in wastewater treatment: In wastewater treatment, sodium alginate is used to accelerate the removal of pollutants and heavy metals. It can form complexes with metal ions, facilitating their precipitation and removal from water. Additionally, it can be used in the development of advanced filtration membranes to enhance water purification processes.
02 Wound healing applications
Sodium alginate is utilized in wound dressings and healing applications. Its ability to absorb exudates and maintain a moist environment accelerates the healing process. When combined with other bioactive compounds, it can enhance tissue regeneration and reduce inflammation.Expand Specific Solutions03 Food and beverage industry applications
In the food and beverage industry, sodium alginate is used as a thickening and stabilizing agent. It can accelerate the gelation process in various products, improving texture and stability. This property is particularly useful in the production of restructured foods and as an emulsifier in beverages.Expand Specific Solutions04 Bioprinting and tissue engineering
Sodium alginate is employed in bioprinting and tissue engineering applications. Its ability to form hydrogels quickly upon exposure to calcium ions allows for rapid fabrication of 3D structures. This property accelerates the development of scaffolds for tissue regeneration and drug screening models.Expand Specific Solutions05 Environmental remediation
In environmental applications, sodium alginate is used to accelerate the removal of pollutants from water and soil. It can form complexes with heavy metals and organic contaminants, facilitating their extraction or immobilization. This property is utilized in water treatment processes and soil remediation techniques.Expand Specific Solutions
Key Players in Sodium Alginate and Biocompatible Polymer Industry
The development of biocompatible polymers using sodium alginate is in a growth phase, with increasing market size and technological advancements. The global market for biocompatible polymers is expanding due to rising demand in medical applications. Companies like Hadasit Medical Research Services, Evelo Biosciences, and Cresilon are at the forefront of this technology, leveraging sodium alginate's properties to enhance biocompatibility. Academic institutions such as the University of Washington and Tianjin University are contributing to research and innovation in this field. The technology's maturity is progressing, with ongoing efforts to optimize formulations and explore new applications, indicating a competitive landscape with potential for further growth and innovation.
Cresilon, Inc.
Technical Solution: Cresilon, Inc. has pioneered the use of sodium alginate in developing rapid-acting hemostatic gels. Their proprietary technology leverages the unique properties of sodium alginate to create a biocompatible polymer matrix that quickly forms a stable gel upon contact with blood. This gel effectively seals wounds and promotes rapid clotting. The company's research has shown that their alginate-based hemostatic gel can achieve hemostasis in under 30 seconds for certain types of wounds [2]. Cresilon's approach also involves modifying the alginate structure to enhance its interaction with blood components, resulting in a more effective and faster-acting product compared to traditional hemostatic agents [5].
Strengths: Rapid hemostasis, ease of application, and biocompatibility. Weaknesses: Limited to external wound applications and potential for allergic reactions in some patients.
Progenesis Technologies LLC
Technical Solution: Progenesis Technologies LLC has developed an innovative approach using sodium alginate to accelerate the development of biocompatible polymers for 3D bioprinting applications. Their technology involves creating a composite hydrogel system that combines sodium alginate with other natural and synthetic polymers. This composite material exhibits improved printability, mechanical strength, and cell viability compared to traditional bioinks. The company's research has demonstrated that their alginate-based bioinks can maintain cell viability above 90% for up to 14 days in culture [4]. Additionally, Progenesis has developed a proprietary crosslinking method that allows for rapid gelation of the bioink during the printing process, enabling the creation of complex 3D structures with high resolution [6].
Strengths: Excellent printability, high cell viability, and versatility in creating complex 3D structures. Weaknesses: Potential challenges in long-term stability of printed constructs and limited use in load-bearing applications.
Innovative Sodium Alginate Modifications for Enhanced Biocompatibility
Polyvinyl alcohol/sodium alginate/hydroxyapatite composite fibrous membrane, and preparation method and application thereof
PatentActiveUS11786629B2
Innovation
- A polyvinyl alcohol/sodium alginate/hydroxyapatite composite fibrous membrane is developed, where hydroxyapatite nanoparticles are uniformly dispersed using a sodium alginate-stabilized suspension and electrospinning, achieving a stable and biocompatible membrane that can carry antibiotics or growth factors for enhanced repair.
Bacterial cultures and methods for production of alginate
PatentActiveUS20240117300A1
Innovation
- Development of non-toxic, modified Pseudomonas aeruginosa strains deficient in virulence factors and alginate acetylation enzymes, allowing for controlled alginate production with specific properties.
Regulatory Framework for Biocompatible Materials in Medical Applications
The regulatory framework for biocompatible materials in medical applications plays a crucial role in ensuring the safety and efficacy of products incorporating sodium alginate and other biocompatible polymers. As the development of these materials accelerates, regulatory bodies worldwide have established comprehensive guidelines and standards to govern their use in medical devices and pharmaceutical products.
In the United States, the Food and Drug Administration (FDA) oversees the regulation of biocompatible materials through various pathways, depending on their intended use. For medical devices, the FDA's Center for Devices and Radiological Health (CDRH) evaluates the safety and effectiveness of materials through premarket approval (PMA) or 510(k) clearance processes. The agency has established specific guidance documents for biocompatibility testing, including ISO 10993 series, which outlines the biological evaluation of medical devices.
The European Union has implemented the Medical Device Regulation (MDR) and In Vitro Diagnostic Regulation (IVDR), which came into full effect in 2021 and 2022, respectively. These regulations set stringent requirements for biocompatible materials used in medical applications, emphasizing risk management and post-market surveillance. The European Medicines Agency (EMA) also provides guidelines for the use of biocompatible polymers in drug delivery systems and other pharmaceutical applications.
In Japan, the Pharmaceuticals and Medical Devices Agency (PMDA) regulates biocompatible materials through a classification system based on risk levels. The agency has adopted international standards, such as ISO 10993, while also maintaining specific requirements for certain types of materials and devices.
Globally, the International Organization for Standardization (ISO) has developed numerous standards relevant to biocompatible materials, including ISO 13485 for quality management systems in medical devices and ISO 14971 for risk management in medical devices. These standards are widely recognized and often incorporated into national regulatory frameworks.
As the field of biocompatible polymers advances, regulatory agencies are continuously updating their guidelines to address emerging technologies and materials. For instance, the development of novel biomaterials incorporating sodium alginate has prompted regulatory bodies to consider specific requirements for natural polymer-based products. This includes evaluating the sourcing, processing, and potential variability of these materials to ensure consistent quality and safety.
Manufacturers and researchers working with sodium alginate and other biocompatible polymers must navigate this complex regulatory landscape to bring their innovations to market. Compliance with these regulations often requires extensive documentation, rigorous testing, and ongoing monitoring to demonstrate the safety and efficacy of materials throughout their lifecycle.
In the United States, the Food and Drug Administration (FDA) oversees the regulation of biocompatible materials through various pathways, depending on their intended use. For medical devices, the FDA's Center for Devices and Radiological Health (CDRH) evaluates the safety and effectiveness of materials through premarket approval (PMA) or 510(k) clearance processes. The agency has established specific guidance documents for biocompatibility testing, including ISO 10993 series, which outlines the biological evaluation of medical devices.
The European Union has implemented the Medical Device Regulation (MDR) and In Vitro Diagnostic Regulation (IVDR), which came into full effect in 2021 and 2022, respectively. These regulations set stringent requirements for biocompatible materials used in medical applications, emphasizing risk management and post-market surveillance. The European Medicines Agency (EMA) also provides guidelines for the use of biocompatible polymers in drug delivery systems and other pharmaceutical applications.
In Japan, the Pharmaceuticals and Medical Devices Agency (PMDA) regulates biocompatible materials through a classification system based on risk levels. The agency has adopted international standards, such as ISO 10993, while also maintaining specific requirements for certain types of materials and devices.
Globally, the International Organization for Standardization (ISO) has developed numerous standards relevant to biocompatible materials, including ISO 13485 for quality management systems in medical devices and ISO 14971 for risk management in medical devices. These standards are widely recognized and often incorporated into national regulatory frameworks.
As the field of biocompatible polymers advances, regulatory agencies are continuously updating their guidelines to address emerging technologies and materials. For instance, the development of novel biomaterials incorporating sodium alginate has prompted regulatory bodies to consider specific requirements for natural polymer-based products. This includes evaluating the sourcing, processing, and potential variability of these materials to ensure consistent quality and safety.
Manufacturers and researchers working with sodium alginate and other biocompatible polymers must navigate this complex regulatory landscape to bring their innovations to market. Compliance with these regulations often requires extensive documentation, rigorous testing, and ongoing monitoring to demonstrate the safety and efficacy of materials throughout their lifecycle.
Environmental Impact and Sustainability of Sodium Alginate-Based Polymers
The development of sodium alginate-based polymers has significant implications for environmental sustainability. These biopolymers, derived from renewable marine resources, offer a promising alternative to conventional petroleum-based plastics. Their biodegradability and biocompatibility contribute to reduced environmental impact throughout their lifecycle.
Sodium alginate-based polymers demonstrate excellent potential for reducing plastic pollution. Unlike traditional plastics that persist in the environment for centuries, these biopolymers can degrade naturally within weeks or months, depending on environmental conditions. This rapid biodegradation minimizes the accumulation of plastic waste in landfills and oceans, addressing one of the most pressing environmental challenges of our time.
The production of sodium alginate-based polymers also presents a more sustainable manufacturing process compared to synthetic polymers. The extraction of alginate from seaweed requires less energy and produces fewer greenhouse gas emissions than the production of petroleum-based plastics. Additionally, the cultivation of seaweed for alginate extraction can contribute to carbon sequestration, further enhancing the environmental benefits of these materials.
Water conservation is another area where sodium alginate-based polymers excel. Their hydrophilic nature and ability to form hydrogels make them excellent candidates for applications in agriculture and water treatment. These polymers can improve soil water retention, reducing irrigation needs and promoting sustainable farming practices. In water treatment, they can effectively remove contaminants, contributing to cleaner water resources.
The renewable nature of the raw materials used in sodium alginate-based polymers supports a circular economy model. Seaweed, the primary source of alginate, is a fast-growing and abundant resource that can be sustainably harvested. This reduces dependence on finite fossil fuel resources and promotes the development of local, coastal economies involved in seaweed cultivation and processing.
However, it is important to consider the potential environmental impacts of large-scale seaweed farming for alginate production. Careful management is necessary to prevent disruption of marine ecosystems and ensure sustainable harvesting practices. Research into optimizing cultivation methods and exploring alternative sources of alginate, such as microalgae, is ongoing to further enhance the sustainability of these materials.
As the demand for eco-friendly materials grows, sodium alginate-based polymers are poised to play a crucial role in sustainable product development. Their environmental benefits, coupled with their versatile properties, make them attractive for various industries seeking to reduce their ecological footprint. Continued research and development in this field will likely lead to even more sustainable and efficient production methods, further solidifying the position of sodium alginate-based polymers as key players in the transition towards a more sustainable future.
Sodium alginate-based polymers demonstrate excellent potential for reducing plastic pollution. Unlike traditional plastics that persist in the environment for centuries, these biopolymers can degrade naturally within weeks or months, depending on environmental conditions. This rapid biodegradation minimizes the accumulation of plastic waste in landfills and oceans, addressing one of the most pressing environmental challenges of our time.
The production of sodium alginate-based polymers also presents a more sustainable manufacturing process compared to synthetic polymers. The extraction of alginate from seaweed requires less energy and produces fewer greenhouse gas emissions than the production of petroleum-based plastics. Additionally, the cultivation of seaweed for alginate extraction can contribute to carbon sequestration, further enhancing the environmental benefits of these materials.
Water conservation is another area where sodium alginate-based polymers excel. Their hydrophilic nature and ability to form hydrogels make them excellent candidates for applications in agriculture and water treatment. These polymers can improve soil water retention, reducing irrigation needs and promoting sustainable farming practices. In water treatment, they can effectively remove contaminants, contributing to cleaner water resources.
The renewable nature of the raw materials used in sodium alginate-based polymers supports a circular economy model. Seaweed, the primary source of alginate, is a fast-growing and abundant resource that can be sustainably harvested. This reduces dependence on finite fossil fuel resources and promotes the development of local, coastal economies involved in seaweed cultivation and processing.
However, it is important to consider the potential environmental impacts of large-scale seaweed farming for alginate production. Careful management is necessary to prevent disruption of marine ecosystems and ensure sustainable harvesting practices. Research into optimizing cultivation methods and exploring alternative sources of alginate, such as microalgae, is ongoing to further enhance the sustainability of these materials.
As the demand for eco-friendly materials grows, sodium alginate-based polymers are poised to play a crucial role in sustainable product development. Their environmental benefits, coupled with their versatile properties, make them attractive for various industries seeking to reduce their ecological footprint. Continued research and development in this field will likely lead to even more sustainable and efficient production methods, further solidifying the position of sodium alginate-based polymers as key players in the transition towards a more sustainable future.
Unlock deeper insights with Patsnap Eureka Quick Research — get a full tech report to explore trends and direct your research. Try now!
Generate Your Research Report Instantly with AI Agent
Supercharge your innovation with Patsnap Eureka AI Agent Platform!